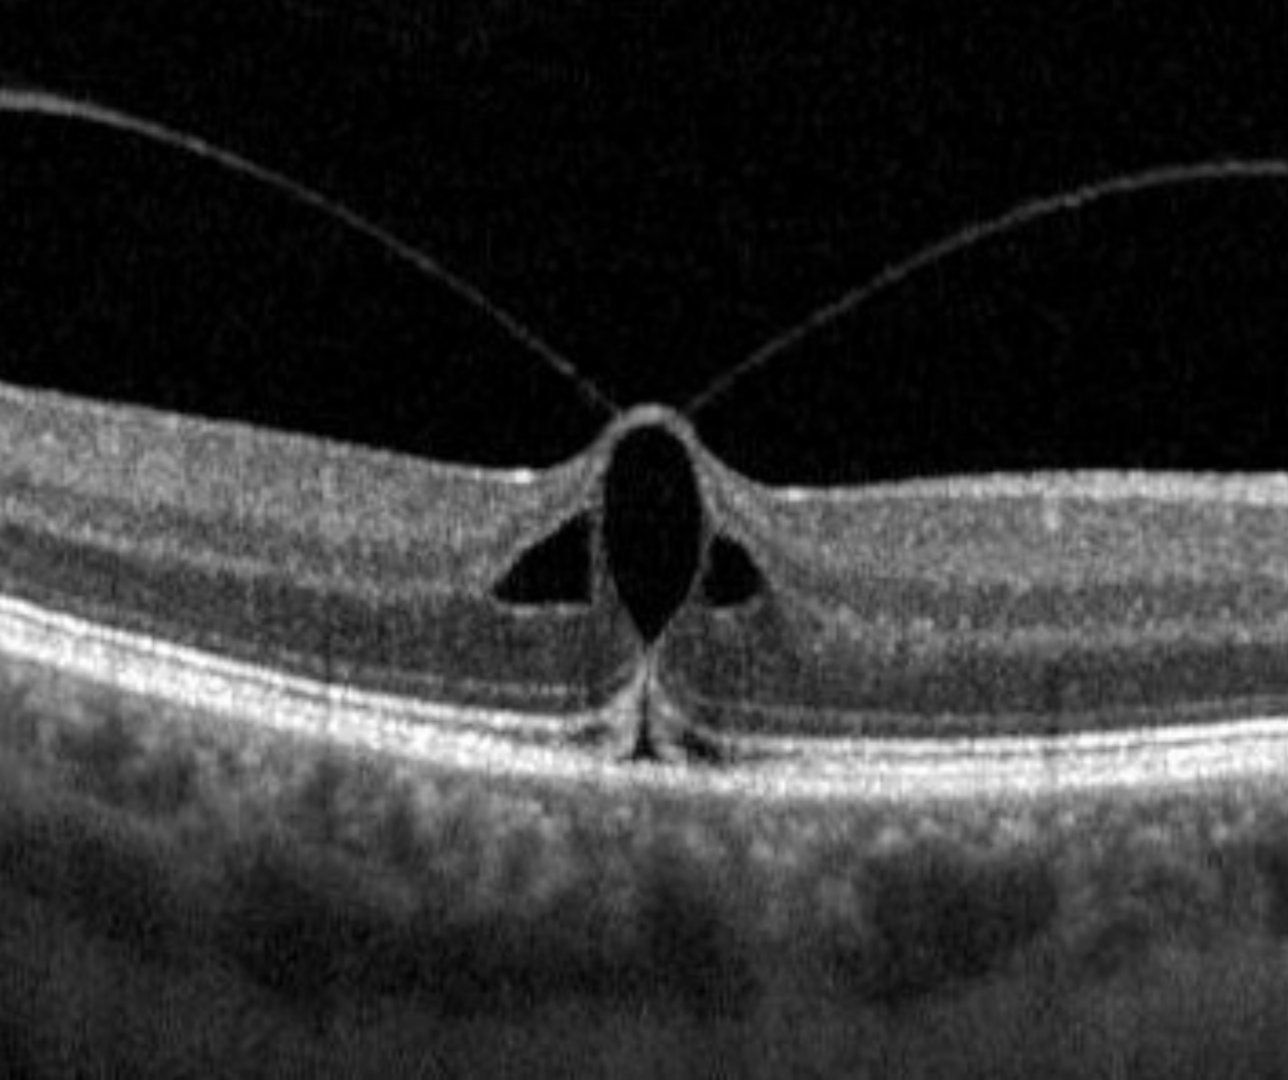

Overview
Vitreomacular traction (VMT) is defined as vitreomacular adhesion and traction within a 3mm radius of the fovea with perifoveal vitreous cortex detachment. It causes distortion of the foveal surface and may be associated with intra retinal abnormalities.
Intra-retinal abnormalities include foveal elevation, schisis, pseudocyst and elevation of the retina from the RPE.
VMT can be defined as a focal (≤1500µm) or broad (>1500µm) adhesion.
Fundus appearance may be normal or show a yellow discolouration of the central macula.
Case examples
-
Case 1
A 57 year old Caucasian female with best corrected visual acuity of 6/7.5 (20/25) in the right eye.
-
Case 2
A 54 year old Caucasian female with best corrected visual acuity of 6/9.5 (20/32) in the right eye. Testing with an Amsler grid showed distortion temporal to fixation.
-
Case 3
A 62 year old Caucasian female with best corrected visual acuity in the left eye of 6/6 (20/20).
-
Case 4
A 67 year old Caucasian female with best corrected visual acuity in the left eye of 6/12 (20/40). Grade 3 nuclear sclerosis was an incidental finding.
-
Case 5
A 73 year old Caucasian male with best corrected visual acuity of 6/7.5 (20/25) in the right eye.
VMT evolution
-
Case 1
This series of radial scans show a patient with Vitreomacular traction in 2021 causing foveal distortion and pseudocysts. By 2022, a full PVD has occurred, releasing traction at the macula. The foveal pit has returned to a near-normal shape, however a pseudocyst is still present adjacent to the fovea
Differential Diagnoses
References
Stalmans, P. Duker, J. Kaiser, PK. Heier, JS. Dugel, P et al. (2013) OCT-Based interpretation of the vitreomacular interface and indications for pharmacologic vitreolysis. Retina Volume 33 - Issue 10